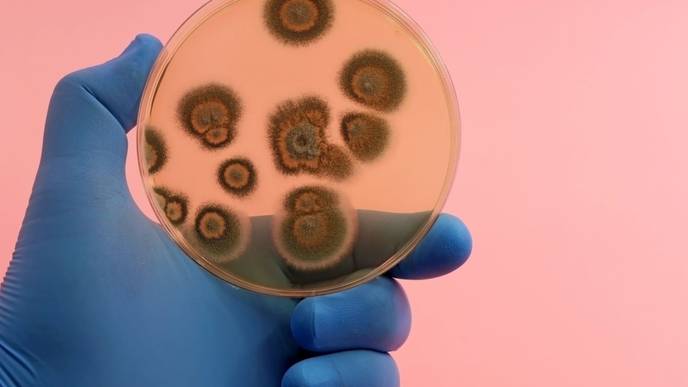
ReachMD Healthcare Image

New Estimate Doubles Likely Deaths from Fungal Disease Globally
01/19/2024
Around a third of 3.23 million chronic obstructive pulmonary disease (COPD) deaths worldwide are linked to infection with the fungus Aspergillus finds Professor Denning.
Though pulmonary tuberculosis was classified as the cause of death in 1.2 million people in 2019, as many as 340,000 (28%) of these could actually be fungal disease deaths he estimates.
Of the estimated 311,594 leukaemia deaths globally in 2020, 14,000 (4.5%) could be attributable to aspergillosis, and some to other fungal infections they find.
Lung and bronchus cancer annual deaths stand at 1.8 million, with the new estimate indicating that aspergillosis is implicated in 49,000 deaths (2.7%) of them.
Candida -another type of fungal infection-is a serious problem in intensive care, complex surgical patients, diabetes, cancer and renal failure, as well as premature babies.
The researchers estimate that about 1.57 million people suffer from Candida bloodstream infection or invasive candidiasis with 995,000 deaths (63.6%), each year.
Professor Denning said: “This work is the first global comprehensive annual incidence estimate of fungal disease, yet many gaps and uncertainties remain.
“Our prior estimates of annual mortality were 1.5 to 2 million, yet we now find the probable number dying with or of a fungal infection is double this at about 3.75 million.
“This estimate was inspired by massive changes in fungal disease awareness and diagnostic capabilities driven by Global Action For Fungal Infections (GAFFI), working in partnership with The University of Manchester, the Fungal Infection Trust, CIFAR’s Fungal Kingdom: Threats and Opportunities program and GAFFI’s global Ambassador network.
“This work would also not have been possible without the remarkable collaboration of over 300 professionals across the world who contributed to published estimates for their country and individual fungal diseases.”
